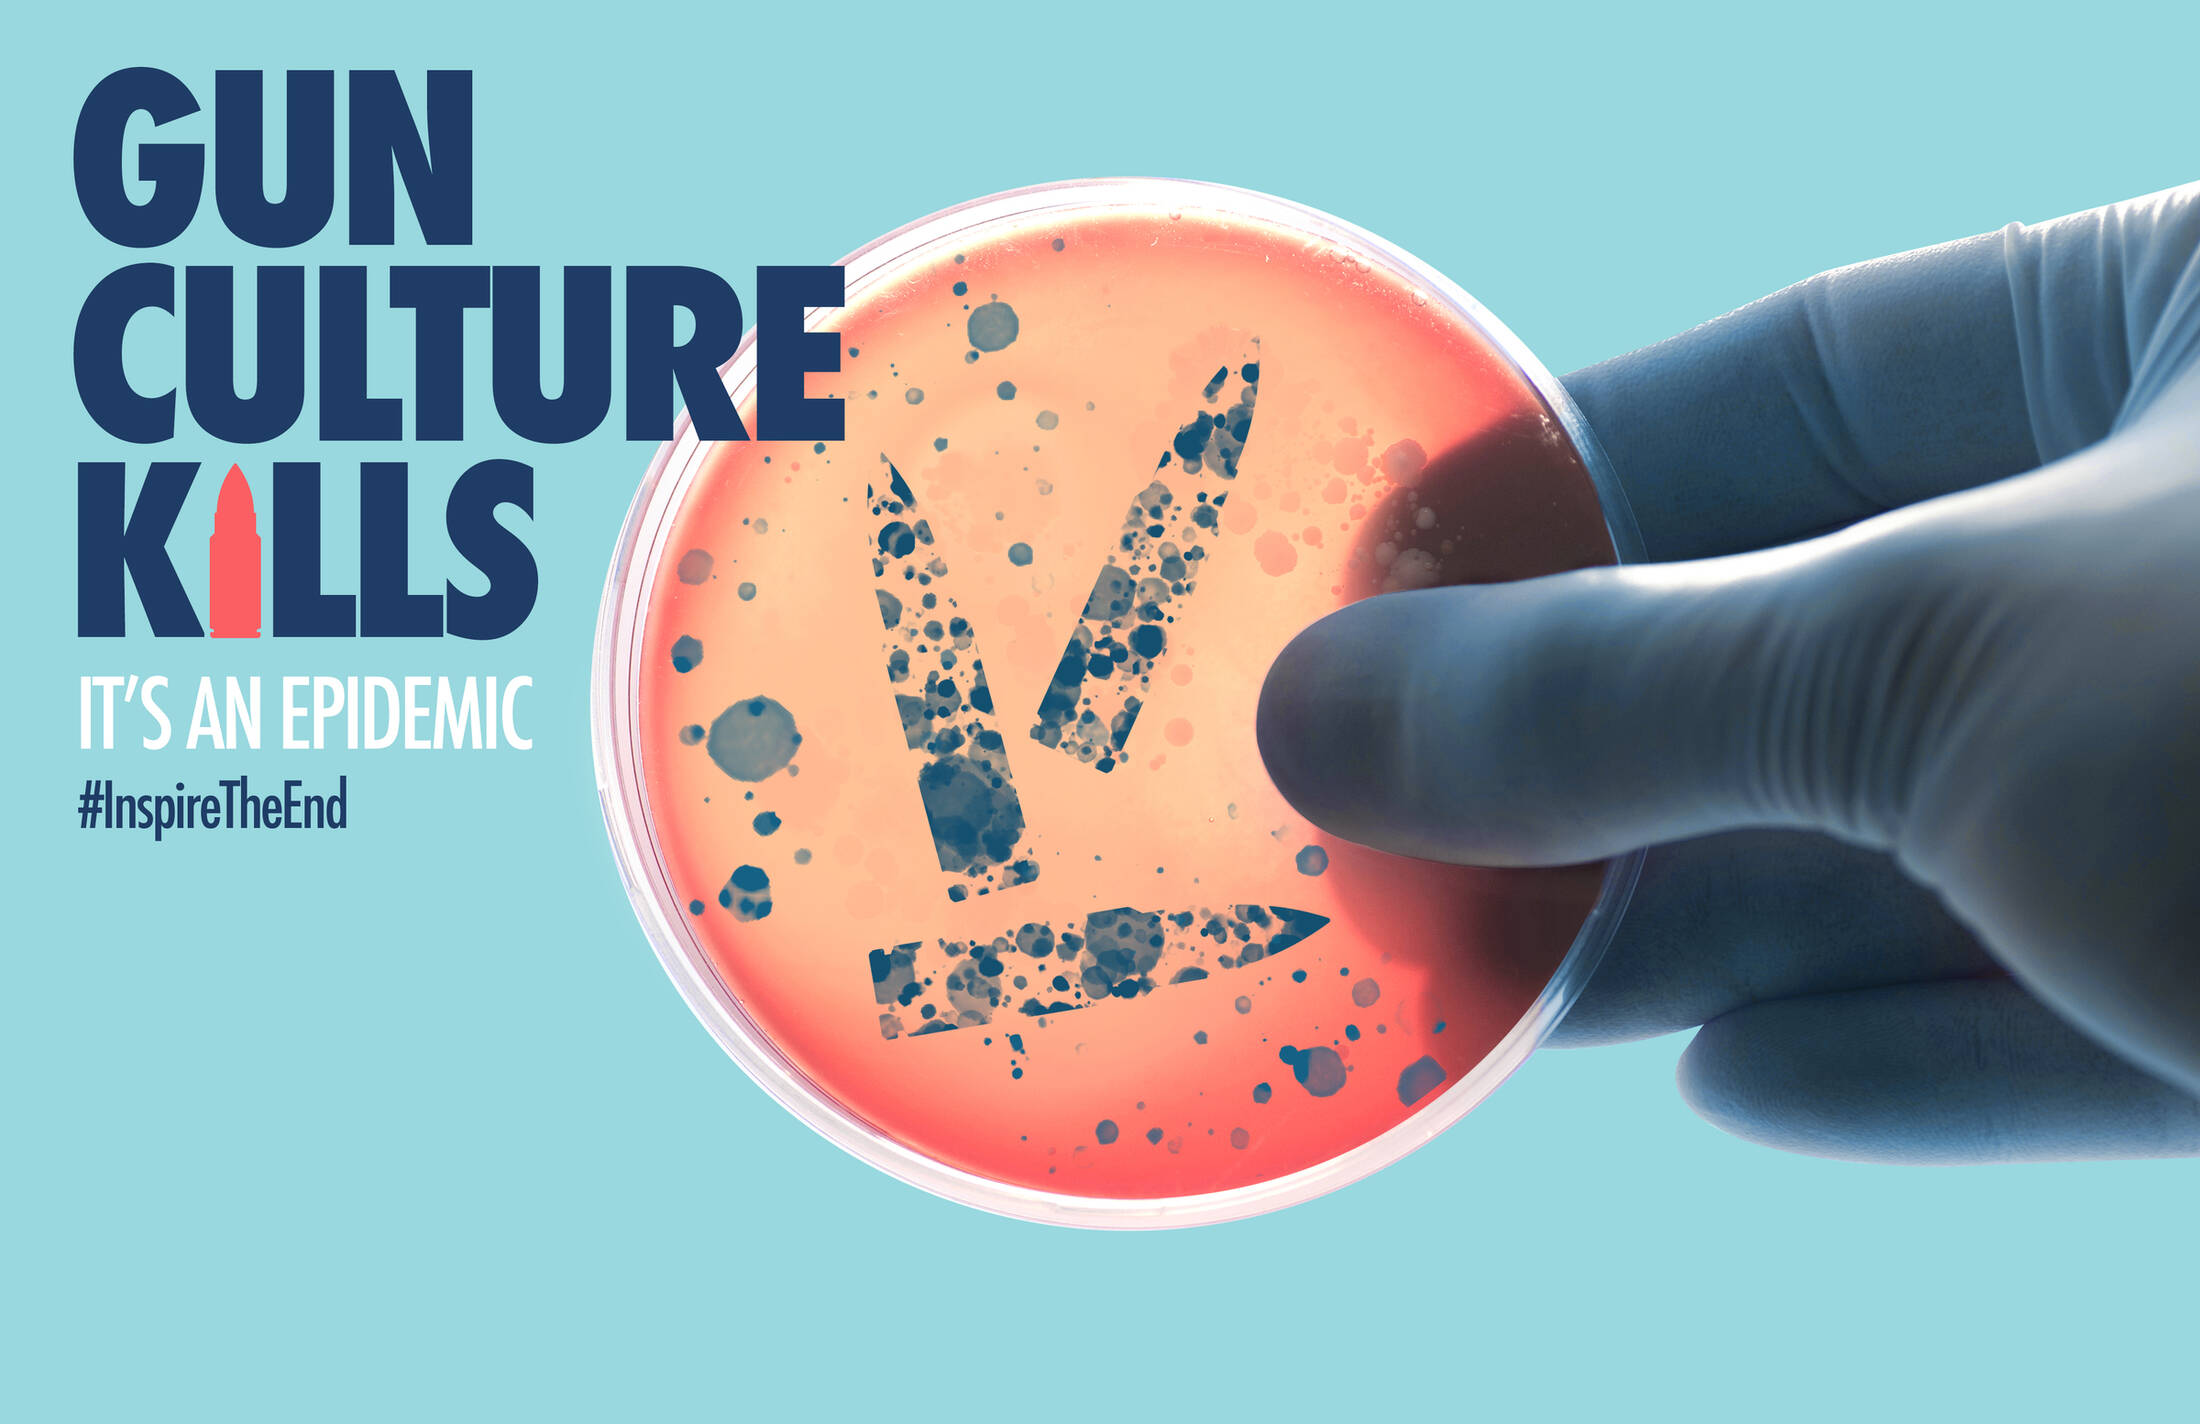
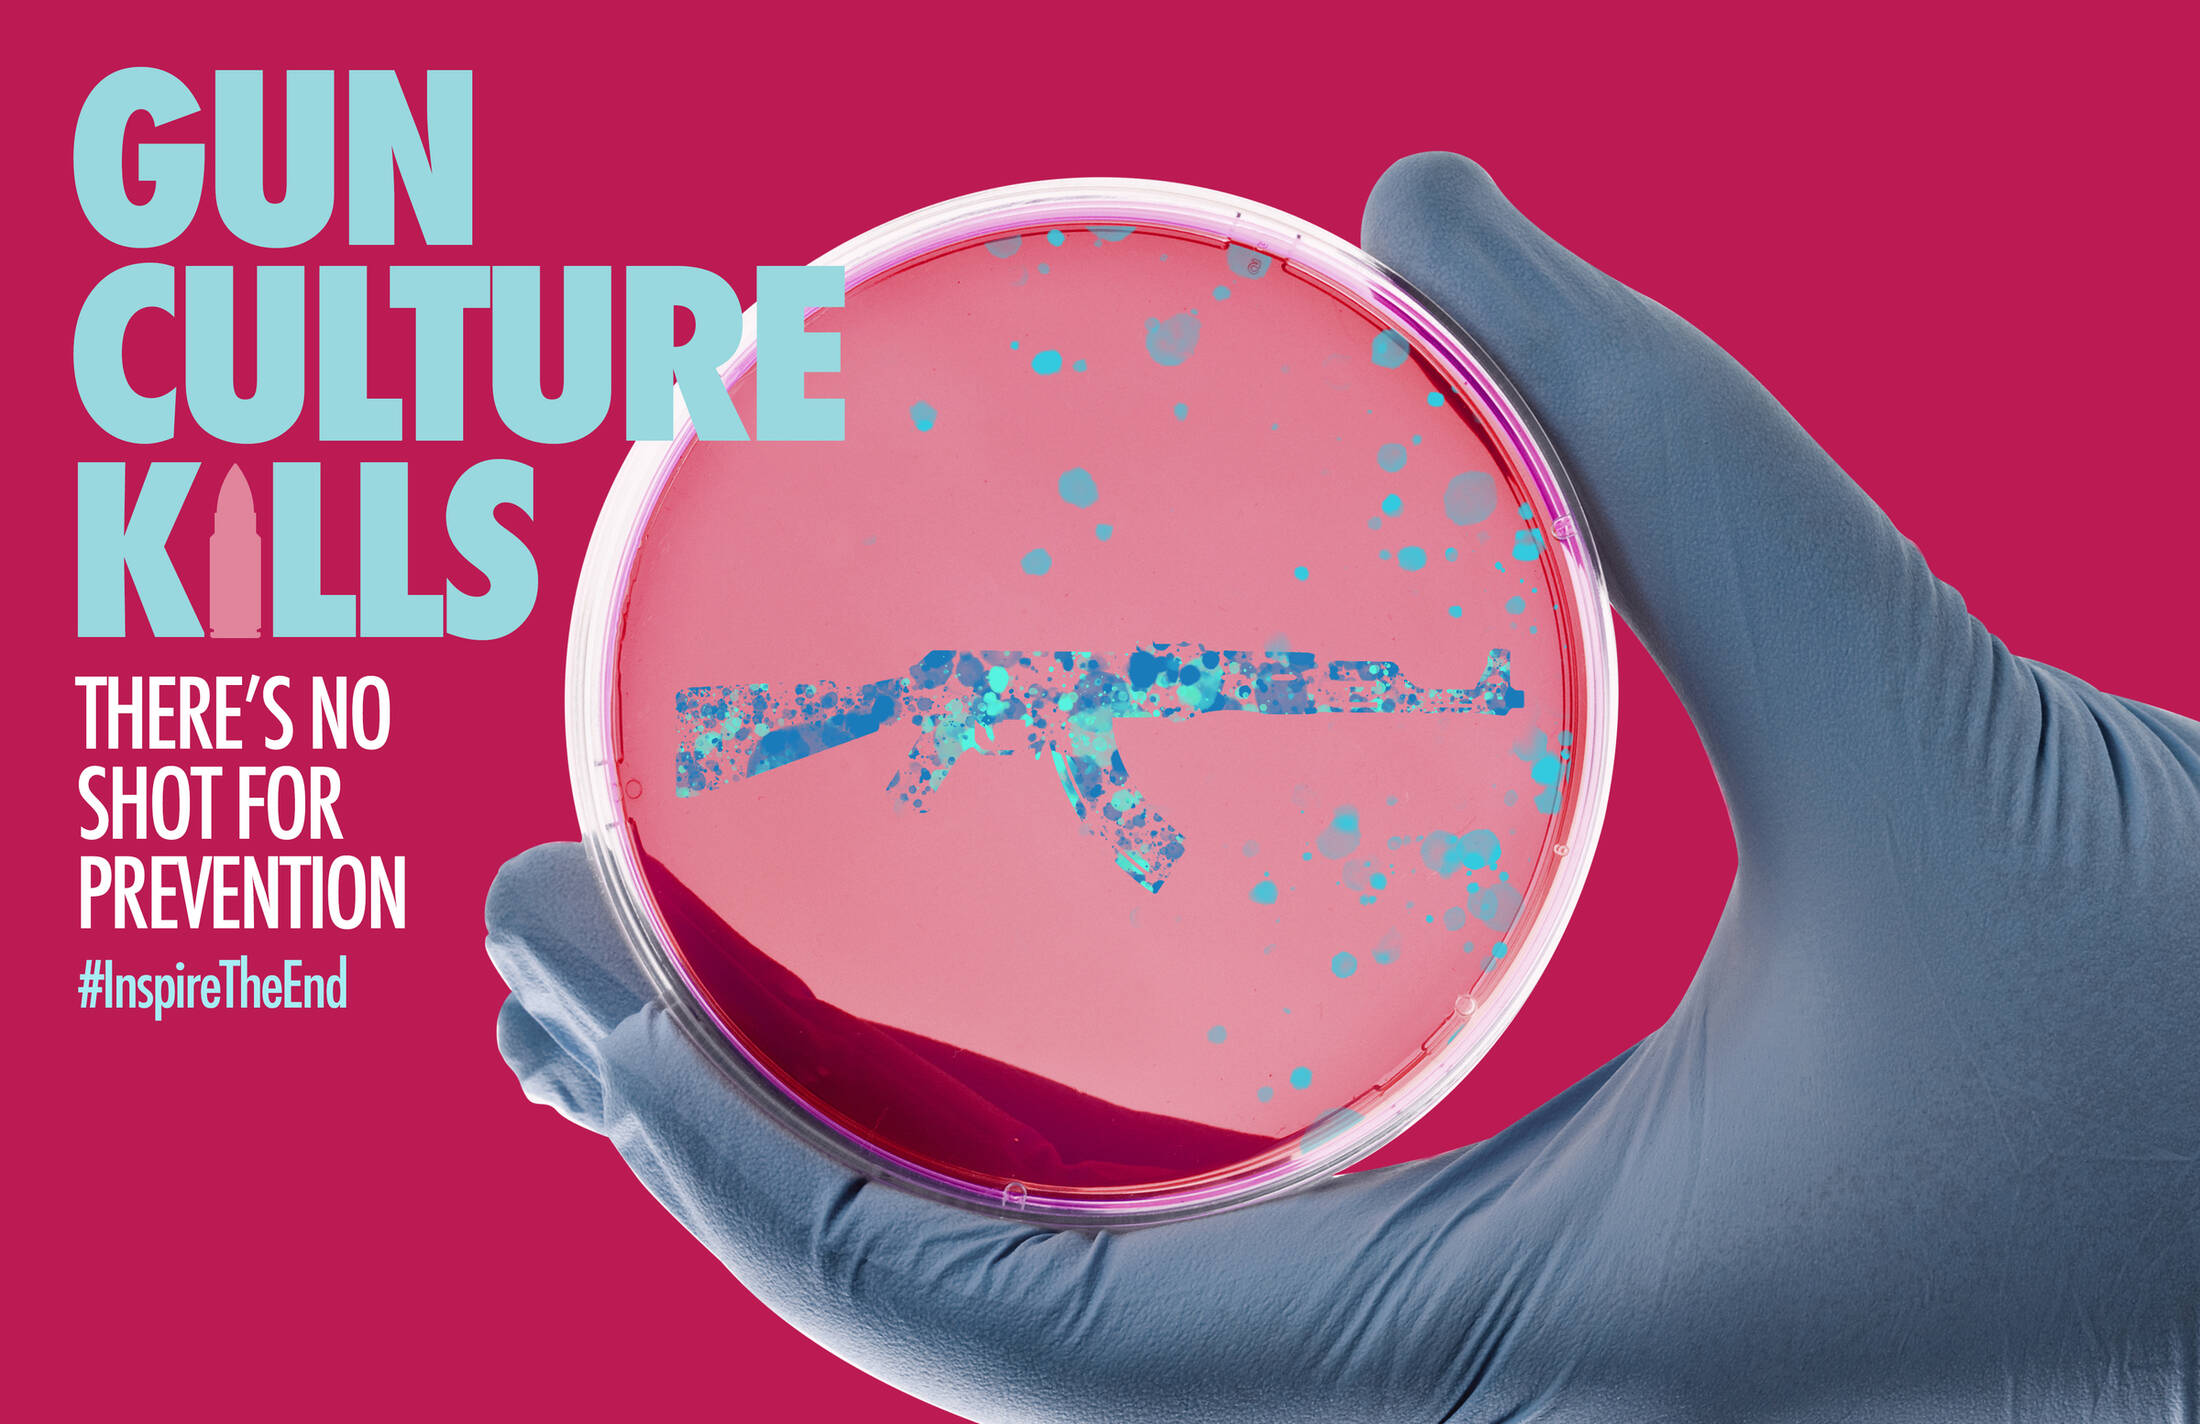

Description
MM&M Magazine launched an initiative to bring awareness to the rampant gun violence that affects the American population. They wanted to encourage a new approach to addressing the problem that could inspire action, with a focus on communicating the impact of gun violence on health and wellness.
This professional campaign titled 'Gun Culture' was published in Canada in September, 2020. It was created for the brand: MM&M, by ad agency: Ogilvy. This Digital medium campaign is related to the Media and Public Interest industries and contains 3 media assets. It was submitted over 5 years ago by Associate Creative Director: Thembi Lassiter of Ogilvy Health.
Credits
Advertising Agency: Ogilvy Health, Montréal, Canada
Executive Creative Director: Wendy Turner
Creative Director / Copy: Jamie Henderson
Associate Creative Director / Art: Thembi Lassiter







